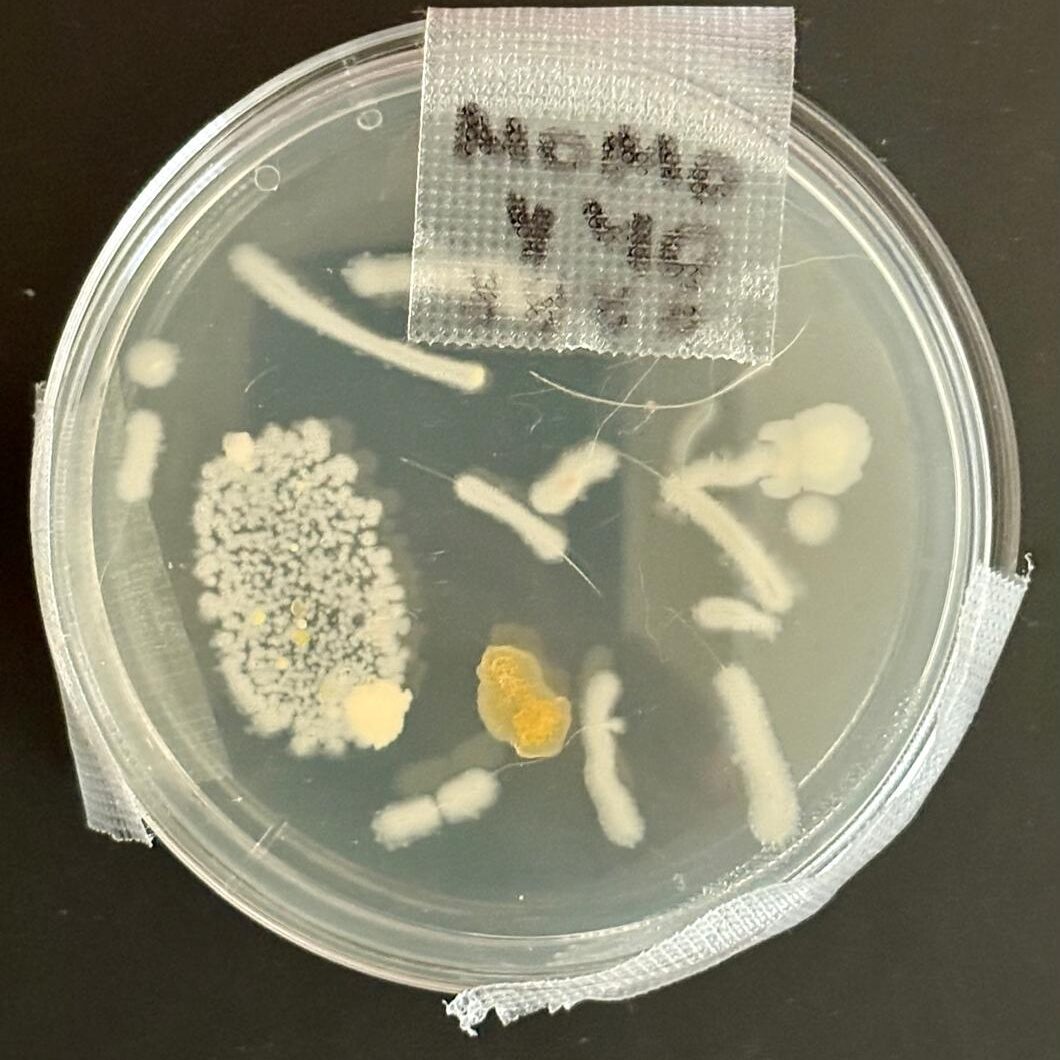
WhatsApp Image 2025-09-06 at 10.39.12 AM (2)

Talleres en línea y presenciales
*Sólo los que tienen acceso, están con inscripciones abiertas
PROGRAMAS ESPECIALES
*Sólo los que tienen acceso, están con inscripciones abiertas

Cómo funcionan nuestros talleres
Cada taller se integra de información teórica y práctica que hace que nuestros programas sean tan completos e integrales, no sólo te decimos cómo hacerlo, sino te damos opciones bibliográficas, referenciales, materiales y te mostramos proyectos afines a nivel mundial y en México.
Qué incluyen nuestros talleres
Para que el aprendizaje sea significativo nuestros talleres presenciales incluyen los materiales y las herramientas de trabajo y te compartimos dónde puedes adquirirlos después para que sigas experimentando! Nuestros talleres virtuales se integran de tutoriales y recetarios descargables para que tengas todos los detalles de lo que tienes que conseguir.

Paga tu taller (tarjeta crédito/débito)
Puedes pagar con tarjeta de crédito/débito vía nuestra cuenta de PayPal desde cualquier ciudad o país.